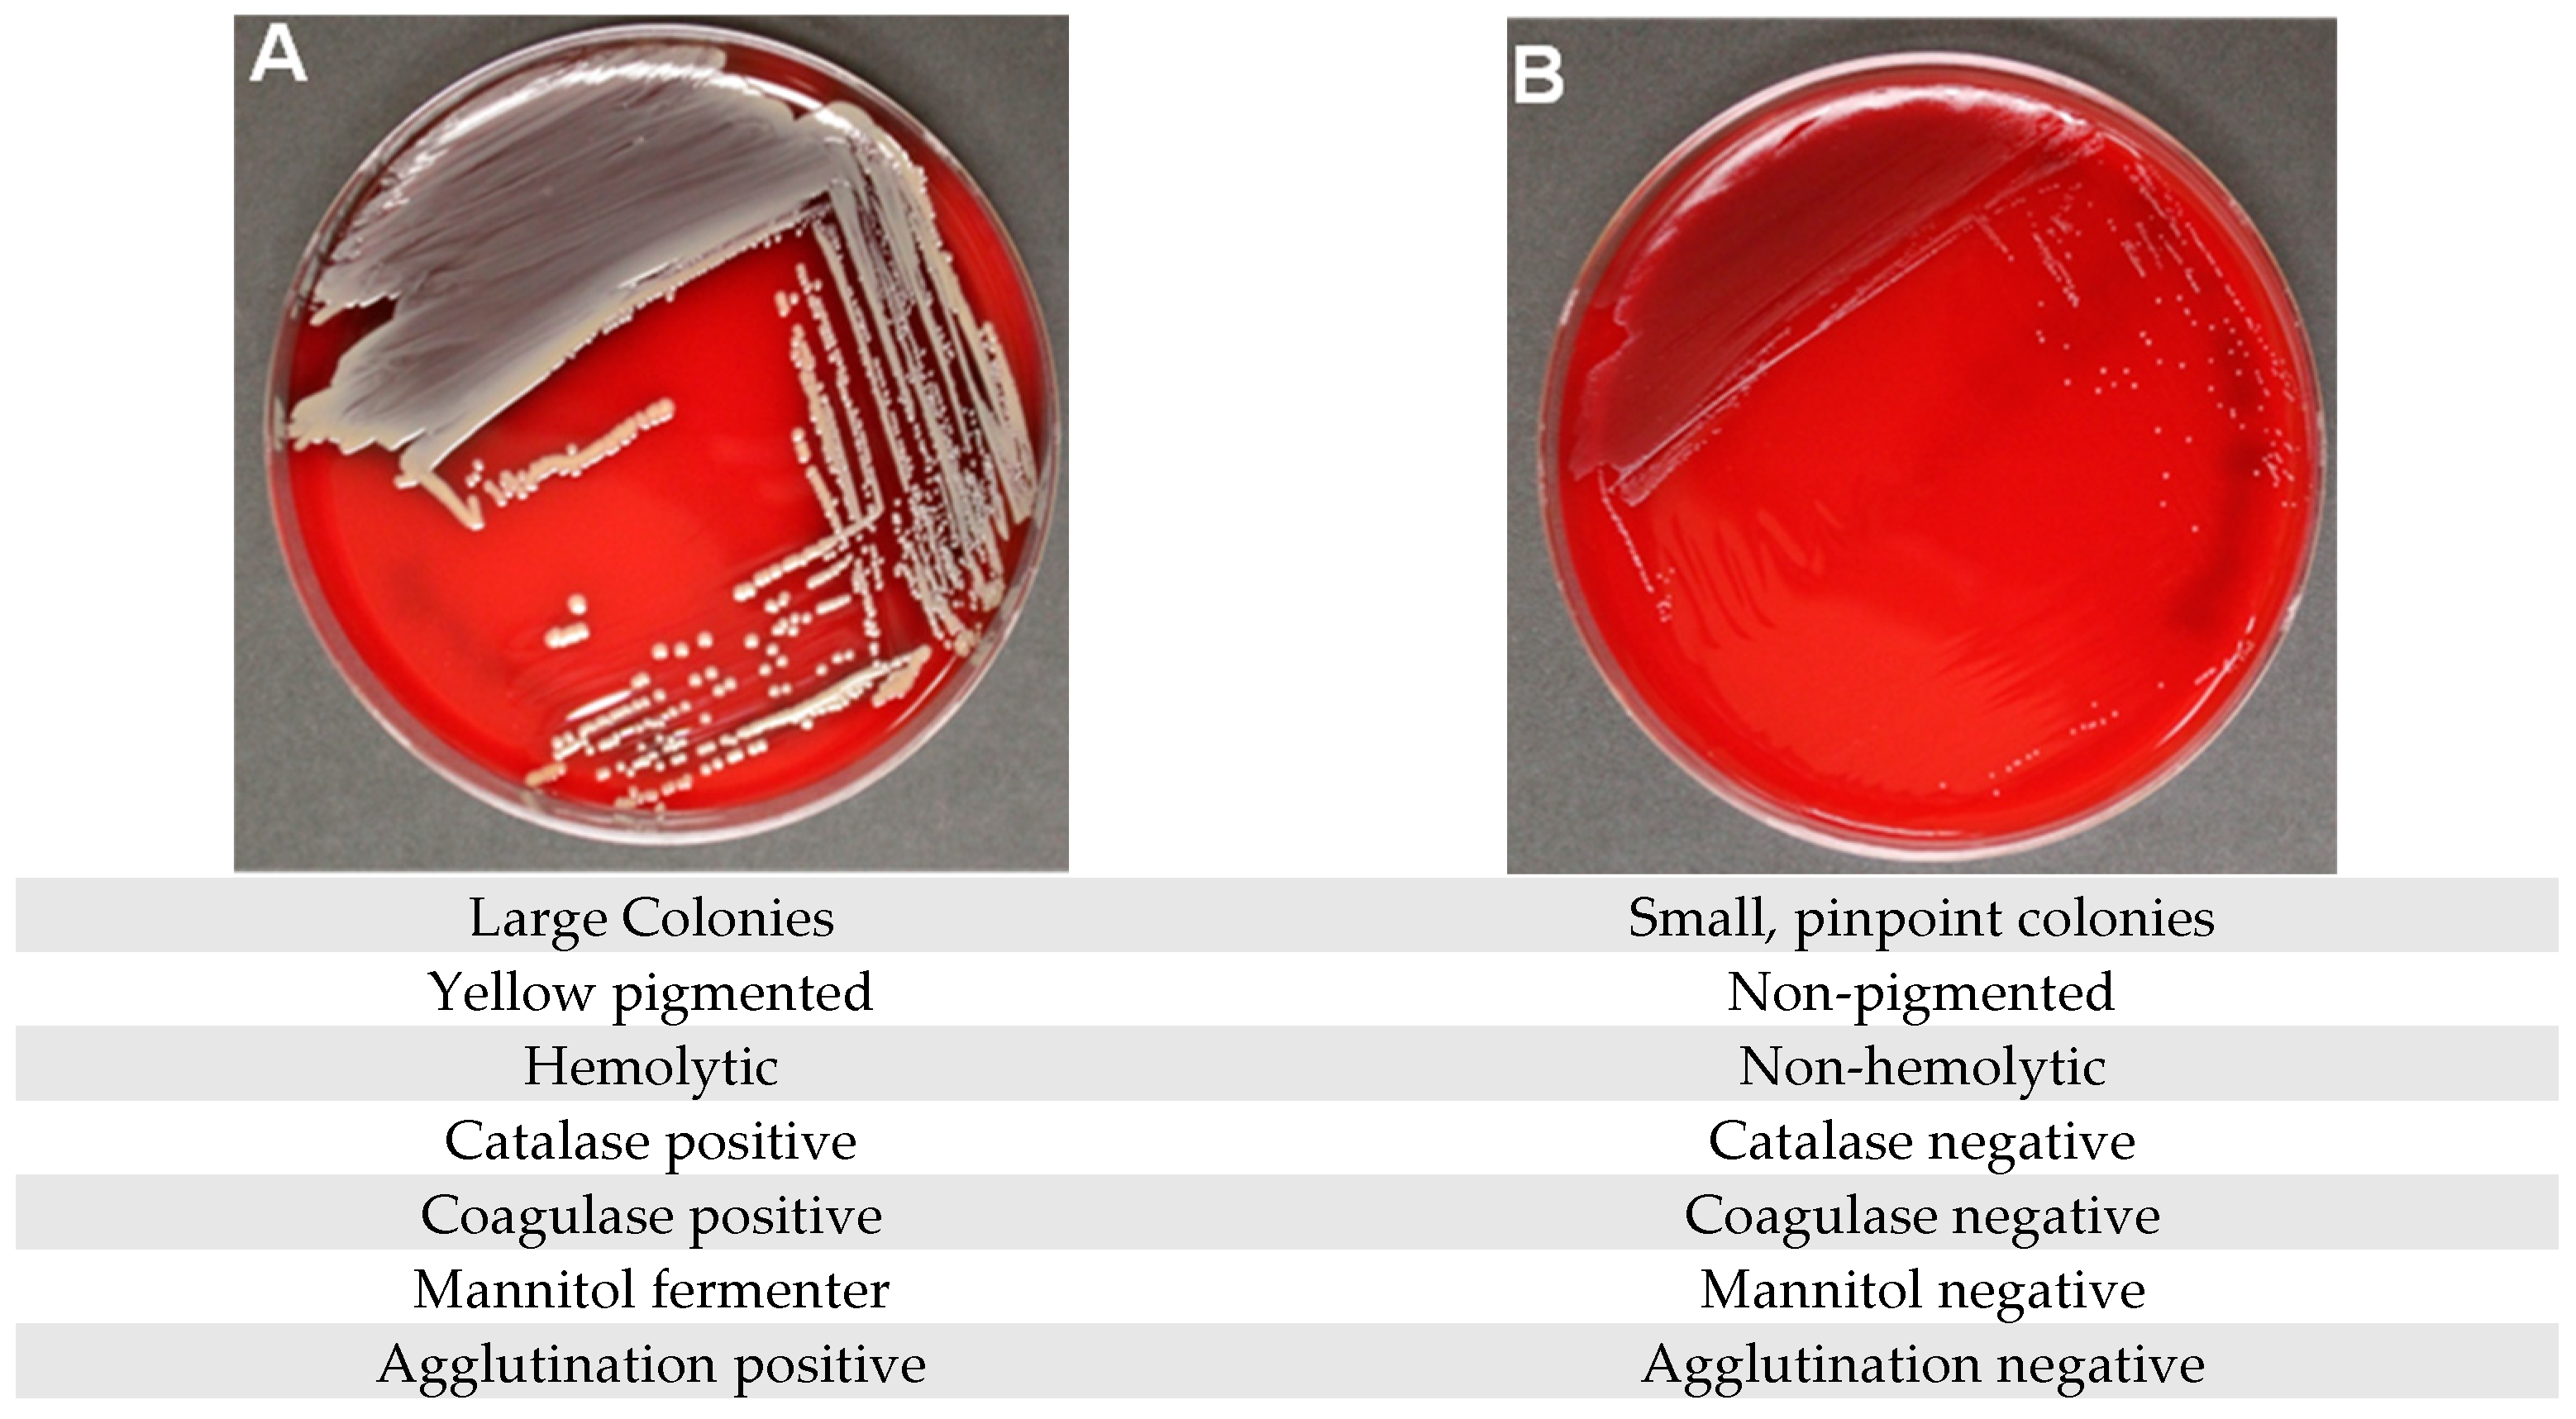
Pathogens 14 01023 g001

Detection and Impact of Staphylococcus aureus Small Colony Variants in Chronic Wounds: A Pilot Study
Abstract
1. Introduction
2. Materials and Methods
2.1. Chronic Wound Sampling
2.2. Culture-Based Biochemical Diagnostics
2.3. In-House Enrichment
2.4. Testing of Suspected SA-SCVs
2.5. Minimum Inhibitory Concentration (MIC) Testing
3. Results
Efficacy of Gold-Standard Testing at Detecting SA-SCVs
4. Discussion
Supplementary Materials
Author Contributions
Funding
Institutional Review Board Statement
Informed Consent Statement
Data Availability Statement
Conflicts of Interest
Abbreviations
| SA-SCV | S. aureus Small-Colony Variant |
| MALDI-TOF | Matrix-Assisted Laser Desorption/Ionization Time-of-Flight mass spectrometry |
References
- Iqbal, A.; Jan, A.; Wajid, M.A.; Tariq, S. Management of Chronic Non-Healing Wounds by Hirudotherapy. World J. Plast. Surg. 2017, 6, 9–17. [Google Scholar]
- Järbrink, K.; Ni, G.; Sönnergren, H.; Schmidtchen, A.; Pang, C.; Bajpai, R.; Car, J. Prevalence and incidence of chronic wounds and related complications: A protocol for a systematic review. Syst. Rev. 2016, 5, 152. [Google Scholar] [CrossRef]
- Cámara, M.; Green, W.; MacPhee, C.E.; Rakowska, P.D.; Raval, R.; Richardson, M.C.; Slater-Jefferies, J.; Steventon, K.; Webb, J.S. Economic significance of biofilms: A multidisciplinary and cross-sectoral challenge. npj Biofilms Microbiomes 2022, 8, 42. [Google Scholar] [CrossRef] [PubMed]
- Highmore, C.J.; Melaugh, G.; Morris, R.J.; Parker, J.; Direito, S.O.L.; Romero, M.; Soukarieh, F.; Robertson, S.N.; Bamford, N.C. Translational challenges and opportunities in biofilm science: A BRIEF for the future. npj Biofilms Microbiomes 2022, 8, 68. [Google Scholar] [CrossRef]
- Edmonds, M.; Manu, C.; Vas, P. The current burden of diabetic foot disease. J. Clin. Orthop. Trauma 2021, 17, 88–93. [Google Scholar] [CrossRef] [PubMed]
- Pecoraro, R.E.; Reiber, G.E.; Burgess, E.M. Pathways to diabetic limb amputation. Basis for prevention. Diabetes Care 1990, 13, 513–521. [Google Scholar] [CrossRef]
- Driver, V.R.; Blume, P.A. Evaluation of Wound Care and Health-Care Use Costs in Patients with Diabetic Foot Ulcers Treated with Negative Pressure Wound Therapy Versus Advanced Moist Wound Therapy. J. Am. Podiatr. Med. Assoc. 2014, 104, 147–153. [Google Scholar] [CrossRef]
- Wolcott, R.D.; Hanson, J.D.; Rees, E.J.; Koenig, L.D.; Phillips, C.D.; Wolcott, R.A.; Cox, S.B.; White, J.S. Analysis of the chronic wound microbiota of 2963 patients by 16S rDNA pyrosequencing. Wound Repair. Regen. 2016, 24, 163–174. [Google Scholar] [CrossRef]
- Pastar, I.; Nusbaum, A.G.; Gil, J.; Patel, S.B.; Chen, J.; Valdes, J.; Stojadinovic, O.; Plano, L.R.; Tomic-Canic, M.; Davis, S.C. Interactions of methicillin resistant Staphylococcus aureus USA300 and Pseudomonas aeruginosa in polymicrobial wound infection. PLoS ONE 2013, 8, e56846. [Google Scholar] [CrossRef]
- Fazli, M.; Bjarnsholt, T.; Kirketerp-Moller, K.; Jorgensen, B.; Andersen, A.S.; Krogfelt, K.A.; Givskov, M.; Tolker-Nielsen, T. Nonrandom distribution of Pseudomonas aeruginosa and Staphylococcus aureus in chronic wounds. J. Clin. Microbiol. 2009, 47, 4084–4089. [Google Scholar] [CrossRef] [PubMed]
- Trivedi, U.; Parameswaran, S.; Armstrong, A.; Burgueno-Vega, D.; Griswold, J.; Dissanaike, S.; Rumbaugh, K.P. Prevalence of Multiple Antibiotic Resistant Infections in Diabetic Versus Nondiabetic Wounds. J. Pathog. 2014, 2014, 173053. [Google Scholar] [CrossRef]
- Gjodsbol, K.; Christensen, J.J.; Karlsmark, T.; Jorgensen, B.; Klein, B.M.; Krogfelt, K.A. Multiple bacterial species reside in chronic wounds: A longitudinal study. Int. Wound J. 2006, 3, 225–231. [Google Scholar] [CrossRef]
- Kock, R.; Becker, K.; Cookson, B.; van Gemert-Pijnen, J.E.; Harbarth, S.; Kluytmans, J.; Mielke, M.; Peters, G.; Skov, R.L.; Struelens, M.J.; et al. Methicillin-resistant Staphylococcus aureus (MRSA): Burden of disease and control challenges in Europe. Eurosurveillance 2010, 15, 19688. [Google Scholar] [CrossRef] [PubMed]
- DeLeon, S.; Clinton, A.; Fowler, H.; Everett, J.; Horswill, A.R.; Rumbaugh, K.P. Synergistic Interactions of Pseudomonas aeruginosa and Staphylococcus aureus in an In Vitro Wound Model. Infect. Immun. 2014, 82, 4718–4728. [Google Scholar] [CrossRef] [PubMed]
- Kaplan, M.L.; Dye, W. Growth requirements of some small-colony-forming variants of Staphylococcus aureus. J. Clin. Microbiol. 1976, 4, 343–348. [Google Scholar]
- Chen, H.; Wang, Q.; Yin, Y.; Li, S.; Niu, D.K.; Wang, H. Genotypic variations between wild-type and small colony variant of Staphylococcus aureus in prosthetic valve infectious endocarditis: A comparative genomic and transcriptomic analysis. Int. J. Antimicrob. Agents 2018, 51, 655–658. [Google Scholar] [CrossRef]
- Conlon, B.P. Staphylococcus aureus chronic and relapsing infections: Evidence of a role for persister cells: An investigation of persister cells, their formation and their role in S. aureus disease. Bioessays 2014, 36, 991–996. [Google Scholar] [CrossRef]
- Keim, K.C.; George, I.K.; Reynolds, L.; Smith, A.C. The Clinical Significance of Staphylococcus aureus Small Colony Variants. Lab. Med. 2023, 54, 227–234. [Google Scholar] [CrossRef] [PubMed]
- Neut, D.; van der Mei, H.C.; Bulstra, S.K.; Busscher, H.J. The role of small-colony variants in failure to diagnose and treat biofilm infections in orthopedics. Acta Orthop. 2007, 78, 299–308. [Google Scholar] [CrossRef]
- Besier, S.; Smaczny, C.; von Mallinckrodt, C.; Krahl, A.; Ackermann, H.; Brade, V.; Wichelhaus, T.A. Prevalence and clinical significance of Staphylococcus aureus small-colony variants in cystic fibrosis lung disease. J. Clin. Microbiol. 2007, 45, 168–172. [Google Scholar] [CrossRef]
- Abele-Horn, M.; Schupfner, B.; Emmerling, P.; Waldner, H.; Goring, H. Persistent wound infection after herniotomy associated with small-colony variants of Staphylococcus aureus. Infection 2000, 28, 53–54. [Google Scholar] [CrossRef]
- Zhou, S.; Rao, Y.; Li, J.; Huang, Q.; Rao, X. Staphylococcus aureus small-colony variants: Formation, infection, and treatment. Microbiol. Res. 2022, 260, 127040. [Google Scholar] [CrossRef]
- Sendi, P.; Rohrbach, M.; Graber, P.; Frei, R.; Ochsner, P.E.; Zimmerli, W. Staphylococcus aureus small colony variants in prosthetic joint infection. Clin. Infect. Dis. 2006, 43, 961–967. [Google Scholar] [CrossRef]
- Kahl, B.C.; Becker, K.; Loffler, B. Clinical Significance and Pathogenesis of Staphylococcal Small Colony Variants in Persistent Infections. Clin. Microbiol. Rev. 2016, 29, 401–427. [Google Scholar] [CrossRef] [PubMed]
- Orazi, G.; O’Toole, G.A. Pseudomonas aeruginosa Alters Staphylococcus aureus Sensitivity to Vancomycin in a Biofilm Model of Cystic Fibrosis Infection. mBio 2017, 8, 10-1128. [Google Scholar] [CrossRef] [PubMed]
- Biswas, L.; Biswas, R.; Schlag, M.; Bertram, R.; Gotz, F. Small-colony variant selection as a survival strategy for Staphylococcus aureus in the presence of Pseudomonas aeruginosa. Appl. Environ. Microbiol. 2009, 75, 6910–6912. [Google Scholar] [CrossRef] [PubMed]
- Hoffman, L.R.; Deziel, E.; D’Argenio, D.A.; Lepine, F.; Emerson, J.; McNamara, S.; Gibson, R.L.; Ramsey, B.W.; Miller, S.I. Selection for Staphylococcus aureus small-colony variants due to growth in the presence of Pseudomonas aeruginosa. Proc. Natl. Acad. Sci. USA 2006, 103, 19890–19895. [Google Scholar] [CrossRef]
- Fugere, A.; Lalonde Seguin, D.; Mitchell, G.; Deziel, E.; Dekimpe, V.; Cantin, A.M.; Frost, E.; Malouin, F. Interspecific small molecule interactions between clinical isolates of Pseudomonas aeruginosa and Staphylococcus aureus from adult cystic fibrosis patients. PLoS ONE 2014, 9, e86705. [Google Scholar] [CrossRef]
- Kahl, B.C. Small colony variants (SCVs) of Staphylococcus aureus—A bacterial survival strategy. Infect. Genet. Evol. 2014, 21, 515–522. [Google Scholar] [CrossRef]
- Mitchell, G.; Seguin, D.L.; Asselin, A.E.; Deziel, E.; Cantin, A.M.; Frost, E.H.; Michaud, S.; Malouin, F. Staphylococcus aureus sigma B-dependent emergence of small-colony variants and biofilm production following exposure to Pseudomonas aeruginosa 4-hydroxy-2-heptylquinoline-N-oxide. BMC Microbiol. 2010, 10, 33. [Google Scholar] [CrossRef]
- Kipp, F.; Kahl, B.C.; Becker, K.; Baron, E.J.; Proctor, R.A.; Peters, G.; von Eiff, C. Evaluation of two chromogenic agar media for recovery and identification of Staphylococcus aureus small-colony variants. J. Clin. Microbiol. 2005, 43, 1956–1959. [Google Scholar] [CrossRef] [PubMed]
- Gómez-González, C.; Acosta, J.; Villa, J.; Barrado, L.; Sanz, F.; Orellana, M.A.; Otero, J.R.; Chaves, F. Clinical and molecular characteristics of infections with CO2-dependent small-colony variants of Staphylococcus aureus. J. Clin. Microbiol. 2010, 48, 2878–2884. [Google Scholar] [CrossRef]
- Seifert, H.; Wisplinghoff, H.; Schnabel, P.; von Eiff, C. Small colony variants of Staphylococcus aureus and pacemaker-related infection. Emerg. Infect. Dis. 2003, 9, 1316–1318. [Google Scholar] [CrossRef]
- Singhal, N.; Kumar, M.; Kanaujia, P.K.; Virdi, J.S. MALDI-TOF mass spectrometry: An emerging technology for microbial identification and diagnosis. Front. Microbiol. 2015, 6, 791. [Google Scholar] [CrossRef]
- Laham, N.A. Mini-Review: Formation, Antibiotic Resistance and Clinical Outcome of Infections Associated with Small Colony Variants of Staphylococci. In Microbial Pathogens and Strategies for Combating Them: Science, Technology and Education; Formatex Research Center: Norristown, PA, USA, 2013. [Google Scholar]
- Ahmed, M.O. Small colony variants of Staphylococcus aureus: A clinical and laboratory challenge. Indian J. Med. Microbiol. 2015, 33, 296–297. [Google Scholar] [CrossRef]
- Bhattacharyya, S.; Kumar, A. Study of Prevalence, Antibiogram and Virulence Determinants of Small Colony Variants of Different Bacteria Isolated in a Tertiary Care Hospital. Int. J. Med. Res. Prof. 2017, 3, 187–189. [Google Scholar]
- Stoneham, S.M.; Cantillon, D.M.; Waddell, S.J.; Llewelyn, M.J. Spontaneously Occurring Small-Colony Variants of Staphylococcus aureus Show Enhanced Clearance by THP-1 Macrophages. Front. Microbiol. 2020, 11, 1300. [Google Scholar] [CrossRef] [PubMed]
- Singh, R.; Ray, P.; Das, A.; Sharma, M. Enhanced production of exopolysaccharide matrix and biofilm by a menadione-auxotrophic Staphylococcus aureus small-colony variant. J. Med. Microbiol. 2010, 59, 521–527. [Google Scholar] [CrossRef]
- Proctor, R.A.; Kriegeskorte, A.; Kahl, B.C.; Becker, K.; Löffler, B.; Peters, G. Staphylococcus aureus Small Colony Variants (SCVs): A road map for the metabolic pathways involved in persistent infections. Front. Cell Infect. Microbiol. 2014, 4, 99. [Google Scholar] [CrossRef]

| Sample | PID from Whole Tissue Submitted to CMC (Lubbock, TX, USA) Evaluated on BD Phoenix | PID of Pure Cultures Evaluated on BD Phoenix (CMC, Lubbock, TX, USA) | Pure Culture Evaluated on MALDI-TOF Testing (CMC, Lubbock, TX, USA) | Confirmatory Testing Evaluated Using NGS Techniques (RTLGenomics, Lubbock, TX, USA) |
|---|---|---|---|---|
| Specimen 1 | Coagulase-negative Staphylococci, diphtheroids | N/A | N/A | N/A |
| Specimen 2 | Coagulase-negative Staphylococci, MRSA | Micrococcus luteus | Janibacter hoylei | Janibacter spp. (16S amplicon); <LOD 16S qPCR |
| Specimen 3 | Coagulase-negative Staphylococci | Candida parapsilosis | Yeast spp. | Fungus, unspecified (ITS amplicon) |
| Specimen 4 | MRSA | N/A | N/A | N/A |
| Specimen 5 | MRSA | Enterococcus faecalis | Enterococcus faecalis | E. faecalis (16S amplicon) |
| Specimen 6 | Coagulase-negative Staphylococci | N/A | N/A | N/A |
| Specimen 7 | Coagulase-negative Staphylococci, diphtheroids | Corynebacterium jeikeium | Corynebacterium jeikeium | <LOD SA qPCR |
| Specimen 8 | MRSA | Staphylococcus warneri | S. aureus | S. aureus SA qPCR |
| Specimen 9 | Gram negative rods (Not Pseudomonas spp.) | Candida parapsilosis, Acinetobacter baumannii | Candida parapsilosis | Fungus, unspecified (ITS amplicon) |
| Specimen 10 | Diphtheroids | Corynebacteria amycolat/ striat | Corynebacterium striatum group | <LOD SA qPCR |
Disclaimer/Publisher’s Note: The statements, opinions and data contained in all publications are solely those of the individual author(s) and contributor(s) and not of MDPI and/or the editor(s). MDPI and/or the editor(s) disclaim responsibility for any injury to people or property resulting from any ideas, methods, instructions or products referred to in the content. |
© 2025 by the authors. Licensee MDPI, Basel, Switzerland. This article is an open access article distributed under the terms and conditions of the Creative Commons Attribution (CC BY) license (https://creativecommons.org/licenses/by/4.0/).
Share and Cite
Carris, E.; Keim, K.C.; Reynolds-Reber, L.; George, I.K.; Sanford, N.; Navarro-Garcia, R.; Lenzmeier, T.D.; Smith, A.C. Detection and Impact of Staphylococcus aureus Small Colony Variants in Chronic Wounds: A Pilot Study. Pathogens 2025, 14, 1023. https://doi.org/10.3390/pathogens14101023
Carris E, Keim KC, Reynolds-Reber L, George IK, Sanford N, Navarro-Garcia R, Lenzmeier TD, Smith AC. Detection and Impact of Staphylococcus aureus Small Colony Variants in Chronic Wounds: A Pilot Study. Pathogens. 2025; 14(10):1023. https://doi.org/10.3390/pathogens14101023
Chicago/Turabian StyleCarris, Eleanna, Klara C. Keim, Landrye Reynolds-Reber, Isaiah K. George, Nicholas Sanford, Rocio Navarro-Garcia, Taylor D. Lenzmeier, and Allie Clinton Smith. 2025. "Detection and Impact of Staphylococcus aureus Small Colony Variants in Chronic Wounds: A Pilot Study" Pathogens 14, no. 10: 1023. https://doi.org/10.3390/pathogens14101023
APA StyleCarris, E., Keim, K. C., Reynolds-Reber, L., George, I. K., Sanford, N., Navarro-Garcia, R., Lenzmeier, T. D., & Smith, A. C. (2025). Detection and Impact of Staphylococcus aureus Small Colony Variants in Chronic Wounds: A Pilot Study. Pathogens, 14(10), 1023. https://doi.org/10.3390/pathogens14101023

